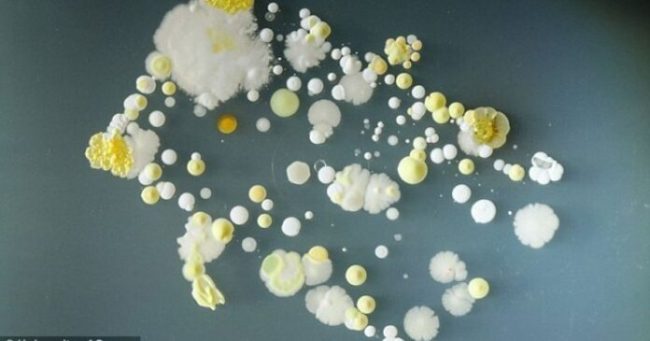

Ученые обнаружили в организме естественные антидепрессанты, которые действуют, как кетамин — МедНовости
26 февраля 2020 года, 16:30 Когда иммунная система атакует ткани собственного организма, развиваются тяжелые аутоиммунные заболевания. Немецкие ученые обнаружили необычный феномен: антитела против определенных рецепторов в головном мозге могут снижать уровень тревожности и депрессии. Отчет об их исследовании опубликован в журнале Molecular Psychiatry. NMDA-рецепторы в клетках головного мозга участвуют процессах обучения и работе памяти. В…